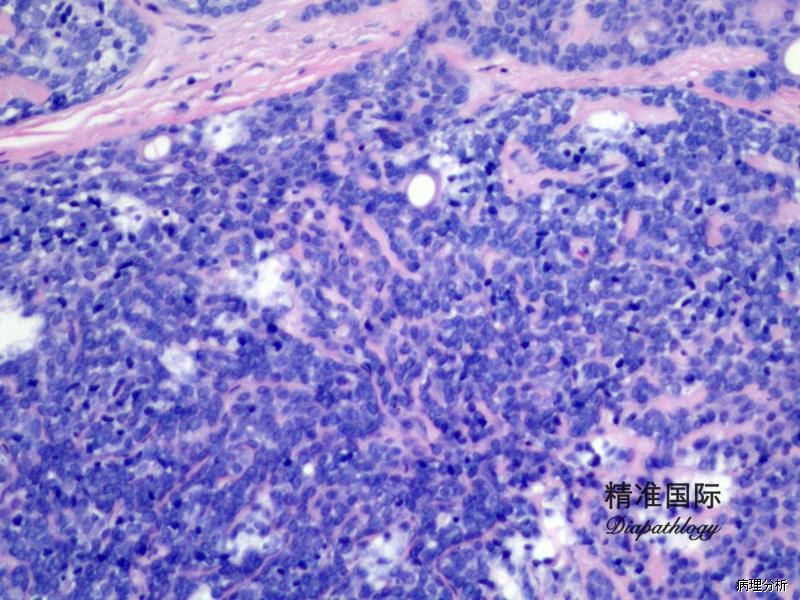

小汗腺螺旋腺瘤
Eccrine Spiradenoma
概述:
良性皮肤附属器肿瘤,由基底细胞样结节构成,伴小汗腺甚至大汗腺分化
发病部位: 好发于头、颈、躯干部
诊断要点:
多见于青少年,好发于头、颈、躯干部,表现为单个或多发圆形或椭圆形界限清楚的皮下结节;
瘤体位于真皮深层,由多个或单个小叶组成,与表皮不相连,可有不完整的包膜;
小叶周边细胞体积小,基底细胞样,胞浆少,核圆形,深染;小叶中央细胞体积大,核淡染,苍白,胞浆嗜酸性;
细胞巢内有时可见局灶或弥漫小汗腺导管结构,腔内含嗜酸性 PAS 阳性耐淀粉酶物质;
有些病例可见囊性变,囊内可见 PAS 阳性耐淀粉酶物质;
偶尔可伴局灶毛母细胞瘤成分或皮肤淋巴腺瘤成分;
间质可见玻璃样变物,有时可见淋巴细胞浸润;
部分病例间质富于血管。

免疫组织化学染色:
肿瘤细胞显示 CK7、8 及 18 (CAM5.2)、CK5/6 及 p63 阳性;导管 CEA 及 EMA 阳性;部分显示 SMA、calponin 及 S100 阳性(伴肌上皮分化)。
鉴别诊断:
螺旋腺癌 :具细胞异型性和浸润性生长方式。
圆柱瘤 :细胞巢周围可见大量的呈锯齿状分布的嗜酸性基底膜样物。
3. 基底细胞癌: 细胞巢周边细胞呈栅栏状排列,周围有收缩裂隙。
4. Merkel 细胞癌:细胞异型明显,核分裂活跃,免疫组化染色 CK20 阳性,神经内分泌标记 CgA、Syn、CD56 等一种或多种阳性
治疗:
肿瘤完全切除可治愈。
← 汗腺瘤 分泌黏液的内分泌汗腺癌 →
